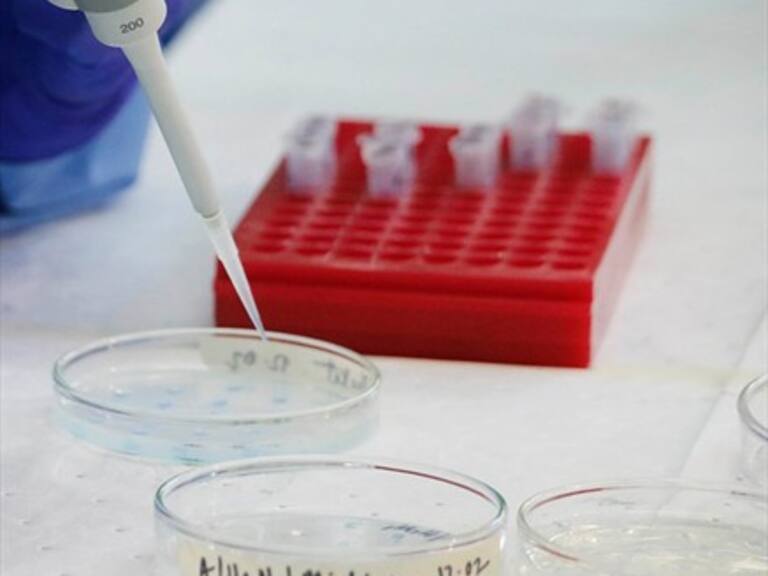
ISP aún no determina el origen de la bacteria que mató a dos lactantes en clínica

ISP aún no determina el origen de la bacteria que mató a dos lactantes en clínica
El instituto determinó que 8 de los 33 menores que consumieron el compuesto presentaron el organismo que resultó fatal para los menores.
El Instituto de Salud Pública de Chile (ISP) determinó que ocho de los 33 recién nacidos que usaron el suplemento alimenticio nutrición parenteral total (NPT) presentaron sintomatología sugerente de infección y presencia de bacteria, similar a la que significó la muerte de dos lactantes en la Clínica Alemana.
Sin embargo, no pudo determinar si el origen del organismo es intrahospitalario o al momento de la preparación de la receta magistral.
Verónica Ramírez, medico laboratorista del ISP, explicó que seguirán estudiando las muestras. "No podemos, con estos hallazgos, concluir la fuente a través de la cual se adquirió la bacteria", dijo.
Las cepas bacterianas encontradas fueron enviadas al Laboratorio Biomédico del ISP para su confirmación, identificándose la presencia de:
Los menores que consumieron el suplemento alimenticio estaban en Clínica Alemana, Hospital Exequiel González Cortés, Hospital Clínico Universidad de Chile, Clínica Bicentenario, Clínica Tabancura, Home Medical.
El ISP continúa analizando las cepas bacterianas recibidas desde los establecimientos, para comparar el patrón genético de ellas a través de estudios de clonalidad, que se realizan en el Laboratorio de Genética Molecular.
Sigue a ADN.cl en Google Discover
Recibe nuestros contenidos directamente en tu feed.























